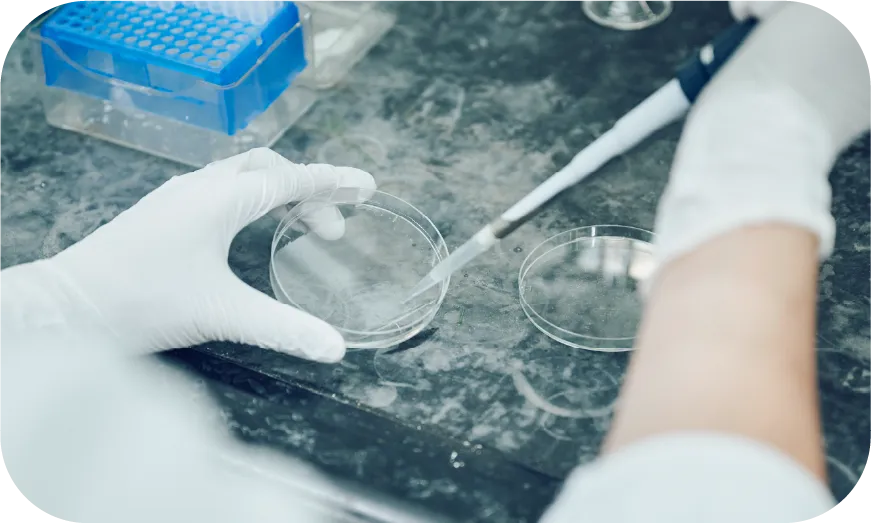
探索

ABOUT
お仕事相関図
多彩な仕事が、ひとつの医療を支えている。
小野薬品では、それぞれの職種が
どんな役割を果たしているのかをお伝えします。
小野薬品では、それぞれの職種が
どんな役割を果たしているのかをお伝えします。
小野薬品で
研究職として働く
研究職として働く
治療満足度が低く、
アンメットメディカルニーズの高い疾患に対する
革新的新薬の創製に挑戦しています。
科学の専門知識だけでなく、
医療現場を理解し、
世界中の大学や
ベンチャーなどとのオープンイノベーションを通じて、
新しいアイデアや最新技術を取り入れながら、
バイオロジーの解明と新薬候補の
創製に取り組んでいます。
また、新薬候補創製後も患者さんに
1日でも早く新薬を届けられるよう
研究の立場でサポートを行います。
アンメットメディカルニーズの高い疾患に対する
革新的新薬の創製に挑戦しています。
科学の専門知識だけでなく、
医療現場を理解し、
世界中の大学や
ベンチャーなどとのオープンイノベーションを通じて、
新しいアイデアや最新技術を取り入れながら、
バイオロジーの解明と新薬候補の
創製に取り組んでいます。
また、新薬候補創製後も患者さんに
1日でも早く新薬を届けられるよう
研究の立場でサポートを行います。
WORKS
研究職の仕事内容
探索
独自の創薬シーズを見出し、それが疾患にどう関与するか、どの創薬モダリティ(医薬品の物質的な種別)で制御できるかを探るため、細胞などを用いた実験と最先端テクノロジーを駆使して研究を行っています。
新薬候補創製
社内外の最新技術を活用し、低分子医薬や抗体医薬、最先端の創薬モダリティを設計・最適化して、新薬候補の創製に取り組みます。

評価
新薬候補の有効性をIn vitro(試験管内)やin vivo(生体内)で確認するほか、安全性や体内動態も評価します。課題が見つかった場合は、真摯に向き合い、チームで解決策を検討します。

SYSTEM
研究職の研修体制

研究職では、「創薬に挑む人財」を育成するために、
入社時導入研修や部門別・現場研修、
法令関連研修をはじめ、3年次のフォローアップ研修や
語学を含めた自己啓発支援など、
段階的かつ体系的に学べる環境を用意しています。
さらに、大学・研究機関・バイオベンチャーとの
オープンイノベーションや留学を通じて、
新薬創製につながる最新の知見や
テクノロジーを学ぶことができます。
患者さん本位の企業文化と、
新領域への挑戦精神が融合する、
研究者として成長できる研修体制です。
入社時導入研修や部門別・現場研修、
法令関連研修をはじめ、3年次のフォローアップ研修や
語学を含めた自己啓発支援など、
段階的かつ体系的に学べる環境を用意しています。
さらに、大学・研究機関・バイオベンチャーとの
オープンイノベーションや留学を通じて、
新薬創製につながる最新の知見や
テクノロジーを学ぶことができます。
患者さん本位の企業文化と、
新領域への挑戦精神が融合する、
研究者として成長できる研修体制です。


TYPE
#小野薬品の研究職は
こんな人
こんな人
研究職の最前線で活躍する先輩社員の
リアルをぜひ覗いてみてください。
リアルをぜひ覗いてみてください。
FLOW
研究職 選考フロー

DETAIL
あなたの“気になる”から、
もっと知る。
もっと知る。
小野薬品という企業について知りたい
ENTRY
熱き挑戦をここから
あなたの「これから」を、小野薬品で。
その想いに、ちゃんと応える場所があります。
その想いに、ちゃんと応える場所があります。










